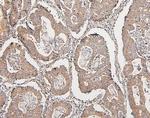
COMT Antibody in Immunohistochemistry (Paraffin) (IHC (P))

Search
Invitrogen
COMT Monoclonal Antibody (15C10)
{{$productOrderCtrl.translations['antibody.pdp.commerceCard.promotion.promotions']}}
{{$productOrderCtrl.translations['antibody.pdp.commerceCard.promotion.viewpromo']}}
{{$productOrderCtrl.translations['antibody.pdp.commerceCard.promotion.promocode']}}: {{promo.promoCode}} {{promo.promoTitle}} {{promo.promoDescription}}. {{$productOrderCtrl.translations['antibody.pdp.commerceCard.promotion.learnmore']}}
图: 1 / 12
COMT Antibody (MA5-49153) in ICC/IF

Please note: We are reviewing Western blot images included in the antibody testing data in our catalog, including those provided by third parties. Unless expressly labeled or annotated as “raw-unedited”, Western blot images included in the antibody testing data in our catalog may have been edited, optimized or otherwise adjusted for presentation.
产品信息
MA5-49153
种属反应
宿主/亚型
分类
类型
克隆号
抗原
偶联物
形式
浓度
规格
纯化类型
保存液
内含物
保存条件
运输条件
RRID
产品详细信息
Adding 0.2 mL of distilled water will yield a concentration of 500 µg/mL.
Human COMT shares 81.9% and 81% amino acid (aa) sequence identity with mouse and rat COMT, respectively.
Positive Control - WB: human HepG2 whole cell, human K562 whole cell, human THP-1 whole cell, human HEK293 whole cell, human A549 whole cell, human Caco-2 whole cell, rat RH35 whole cell, mouse Neuro-2a whole cell. IHC: human intestinal cancer tissue, human mammary cancer tissue, human mammary cancer tissue, human placenta tissue, human lung cancer tissue, mouse testis tissue, rat testis tissue. ICC/IF: A431 cell, MCF7 cell. Flow: K562 cell, U87 cell.|Store at -20°C for one year from date of receipt. After reconstitution, at 4°C for one month. It can also be aliquotted and stored frozen at -20°C for six months. Avoid repeated freeze-thaw cycles.
靶标信息
Catechol-O-methyltransferase catalyzes the transfer of a methyl group from S-adenosylmethionine to catecholamines, including the neurotransmitters dopamine, epinephrine, and norepinephrine. This O-methylation results in one of the major degradative pathways of the catecholamine transmitters. In addition to its role in the metabolism of endogenous substances, COMT is important in the metabolism of catechol drugs used in the treatment of hypertension, asthma, and Parkinson disease. COMT is found in two forms in tissues, a soluble form (S-COMT) and a membrane-bound form (MB-COMT). The differences between S-COMT and MB-COMT reside within the N-termini. Several transcript variants are formed through the use of alternative translation initiation sites and promoters.
仅用于科研。不用于诊断过程。未经明确授权不得转售。
篇参考文献 (0)
生物信息学
蛋白别名: Catechol O-methyltransferase; catechol-O-methyltransferase 1; catecholamine-O-methyltransferase; OTTHUMP00000197749; OTTHUMP00000197750
基因别名: COMT; Comt1; D16Wsu103e; D330014B15Rik
UniProt ID: (Mouse) O88587, (Rat) P22734
Entrez Gene ID: (Mouse) 12846, (Rat) 24267




